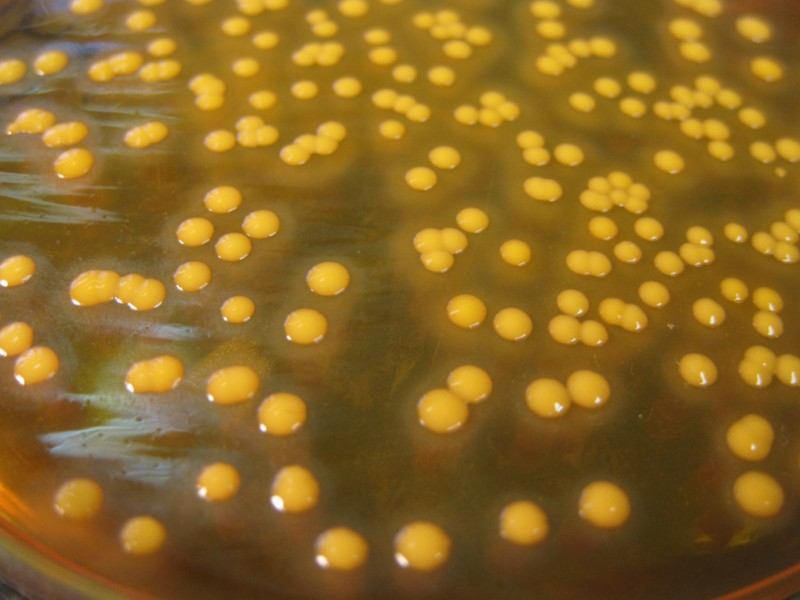
Чому з’являється золотистий стафілокок у вусі і як його лікувати. Стафілокок у вухах: симптоми та особливості лікування

Що являє собою золотистий стафілокок і причини його виникнення
До основних причин цього золотистого стафілокока у вусі відносять наступні:
- передача інфекції повітряно-крапельним шляхом при чханні та кашлі на здорової людини;
- контактно-побутовий шлях передачі інфекції при дотику, а також використання індивідуальних речей хворого здоровою людиною;
- можна захворіти при передачі часток пилу, оскільки пил включає епітелій, а також різні мікроорганізми, в тому числі і віруси, тому вона може бути переносником захворювання;
- при недотриманні гігієни (в даному випадку способом передачі можуть бути слизові, різні виділення, в тому числі блювотні і калові освіти від хворої людини);
- при хірургічному лікуванні (внаслідок недбалого ставлення і недотримання санітарних і стерильних норм можуть бути передані віруси від даного захворювання).
Основними симптомами золотистого стафілокока є наступні:
- зміна кольору шкірних покривів, почервоніння;
- загальне підвищення температури тіла, а також її зміну в області вогнища хвороби;
- збільшення діаметру судин в області почервоніння;
- підвищена чутливість шкіри вуха, неприємні відчуття;
- стан слабкості і нездужання;
- зниження якості слуху (звуження слухового проходу від опухання);
- наявність гнійних утворень;
- загальна картина симптоматики як при інтоксикації.
Золотистий стафілокок розростається дуже швидко. Спочатку недуга практично ніяк не проявляється, і пацієнт може навіть не підозрювати про те, що з ним станеться через кілька днів. Тому вкрай рекомендується дотримуватися всіх заходів профілактики, щоб убезпечити себе і своїх близьких від даного захворювання.
Золотистий стафілокок у вухах – це кулясті грампозитивні пасивні бактерії роду стафілококів
. Переносниками і постійними носіями цих бактерій є 2-40% людей. В організмі з сильним імунітетом вони нейтралізуються захисними силами, і їх діяльність не має продовження.
У ослабленого, виснаженого людини ці бактерії можуть розмножуватися на поверхні шкіри, в носоглотці, але особливо часто – у вухах. Вони викликають сильні вогнищеві запальні процеси і різні захворювання.
Скупчення стафілококів мають схожість з гронами винограду і особливо висока їхня щільність у запалених зонах. Вони можуть вразити людину будь-якої вікової групи та статі. Ситуація ускладнюється тим, що такий вид бактерій дуже добре адаптується до використовуваного лікування та суттєво уповільнює тим самим процес одужання.
Мікробактерії стафілокока викликають такі негативні прояви:
- ураження слухового апарату зі скупченнями некротичних мас;
- пошкодження зовнішніх оболонок шкірних покривів вух;
- розпад волосяних цибулин;
- підвищення згортання крові;
- можуть бути спровоковані алергічні реакції і токсичний шок.
Діти виявляються найбільш сприйнятливими до атаки золотистого стафілокока. Це пов’язано з найбільшою вразливістю дитячого організму до впливу патогенних організмів і недостатніми гігієнічними процедурами.
Якщо на поверхні шкіри є які-небудь ушкодження, то це самий простий шлях потрапляння збудника в організм. Крім того, він може передаватися повітряно-крапельним шляхом, а в порожнину вуха – з допомогою брудних рук.
Однак стафілокок у вусі не завжди може спровокувати захворювання. Для цього повинні бути сприятливі фактори. До них відносяться:
- наявність хронічних захворювань (особливо це хвороби щитовидної залози, цукровий діабет та інші аутоімунні хвороби);
- несприятливі умови зовнішнього середовища;
- знижений імунітет, особливо на фоні лікування антибіотиками та антидепресантами;
- зниження захисних сил організму із-за нестачі вітамінів або сезонних особливостей;
- наркотична залежність;
- систематичні переохолодження організму;
- вірусні та інфекційні захворювання;
- патологічний стан організму, що характеризується зменшенням кількості води в ньому.
Золотистий стафілокок у вухах може з’явитися в рівній мірі як у дітей, так і дорослих. Різниця лише у швидкості розвитку викликається їм інфекції. Якщо вчасно не звернути уваги на зростання вогнища, це може призвести до розвитку гнійного отиту і втрати слуху.
Симптоми, характерні для початку розвитку мікроорганізму, такі:
- гнійні виділення;
- набряк вушної раковини;
- постійний фоновий шум у вухах;
- свербіж з болем у зовнішньому слуховому проході;
- шкірні ушкодження з утворенням кірочок;
- підвищення температури на тлі інтоксикації, загальної слабкості;
- больові відчуття при натиску на козелок;
- поява всередині слухового каналу неприємно пахне зеленої слизу.
Яскравою ознакою того, що оселився саме золотистий стафілокок у вусі, є зміна природного кольору ураженої бактерією зони на золотистий.
Є певне коло людей, яких лікарі заносять в групу ризику по можливому розвитку такого типу захворювань:
- пацієнти, які постійно приймають антибіотики і антидепресанти;
- ті, у кого організм має слабку імунну систему (до цієї категорії належать і діти);
- хворі з порушеннями функцій ендокринної системи, аутоімунними захворюваннями.
Не меншому ризику і схильні люди, що проживають в місцях з поганою екологічною обстановкою.
Якщо у лікаря при огляді хворого з’явиться підозра, що у вусі розвивається золотистий стафілокок, він направить пацієнта на здачу відповідних аналізів (включаючи і антибиотикограмму). Під час їх проведення буде встановлений точний вид бактерії, її чутливість/стійкість до , підібрана ефективна схема лікування, яка зможе знищити мікроорганізми.
Якщо у пацієнта зовнішній отит, то виконується місцеве лікування: закладання у вухо ватних тампонів, просочених необхідним препаратом. Як ліки беруться засоби, що містять поліміксин, неоміцин або кортикостероїди (антибактеріальні краплі, мазі).
У повітрі і на землі широко поширена така бактерія, як стафілокок. Вони часто зустрічаються в організмі людей і тварин. Виділяють кілька видів інфекції, серед яких є як нешкідливі, так і особливо небезпечні віруси для життєдіяльності людини.
Серед них відзначають гемолітичний стафілокок, викликає гнійні запалення; сапрофітний, руйнує сечову систему; епідермальний, негативно діє на шкірний покрив. Але найнебезпечнішим для людини вважається золотистий. Він забарвлює вухо в золотистий відтінок і сильно впливає на загальний стан людини.
Стафілококи
– це круглі бактерії, розташовані у вухах і слизових оболонках. При слабкою імунною системою можуть спровокувати появу безлічі запалень і захворювань.
Інфекція може потрапити у вухо різними шляхами
. Найпоширеніший випадок, коли людина доторкається до органу слуху брудними руками
.
А також спровокувати появу бактерії може нестача вітамінів або сильно ослаблений імунітет.
Таким чином, стафілокок може викликати серйозні захворювання. Наприклад, в середньому вусі або запалення євстахієвої труби.
Крім цього, у вусі можуть з’явитися гнійні виділення і утворення спайок і корочок.
Запущені види стафілококу.
Багато людей думають, що стафілокок може з’явитися тільки в вухах у дітей. Проте, ця думка помилкова
.
Важливо помітити симптоми у момент зародження інфекції. Тоді ви обійдете серйозні наслідки і ускладнення. Неважливо, який саме у вас ураження вуха – золотистий або епідермальний стафілокок. Заходи по лікуванню необхідно прийняти дуже швидко.
Стафілокок провокує появу небезпечних захворювань,
таких як:
- запалення мозкових оболонок;
- інфекційне запалення кісткової тканини. В тому числі захворювання кісток і самого кісткового мозку;
- часткова втрата слуху або ;
- запалення легенів.
Проте найнебезпечнішим
захворюванням вважається загальне зараження організму хвороботворними мікробами, які потрапили в кров.
Перед тим як почати лікування, необхідно звернутися до кваліфікованого фахівця. Він огляне вухо і призначить необхідне лікування. Терапія повинна бути комплексною і включати в себе як лікарські препарати, так і місцеві способи. Отже, чим лікувати стафілокок у вусі?
При легкому захворюванні лікар прописує препарати з антибіотиками
, до складу яких входить неоміцин
. Він міститься в медикаменту під назвою «Дексона
».
Також ефективним дією володіють групи антибіотиків з вузьким спектром активності
під назвою «Поліміксин
».

Використовуйте перераховані засоби у відповідності з інструкцією з застосування . Так ліки буде діяти більш ефективно.
Якщо протягом усього курсу лікування у пацієнта підвищена температура, приймайте жарознижуючі медикаменти
. А також дозволяється застосування зігріваючих компресів.
Зверніть увагу, якщо після застосування антибіотиків хворому не стало краще, необхідно зробити
Дана процедура досить болюча
і проводиться за крайньої необхідності.
В результаті операції
у людини виводиться рідина
, яку обстежують для уточнення діагнозу.
Під час лікування стафілокока, важливо стежити за харчуванням
хворого. Свіжі фрукти та овочі допоможуть ефективного одужання і підвищать стан імунітету людини.
Шляхи зараження стафілококової інфекцією
Проникнення бактерій в слуховий орган в основному відбувається через невеликі ранки і тріщини, які знаходяться в порожнині вуха. Патогенні мікроорганізми потрапляють всередину разом з брудними руками і викликають запальний процес.
Часто на тлі активізації мікробів уражається зовнішня частина вушної раковини, але можливий розвиток запалення і в середньому відділі вуха. Таке поширення мікробів призводить до виникнення такого захворювання, як гнійний отит.
Зараження золотистим стафілококом відбувається наступними способами:
- Повітряно-крапельним шляхом, коли інфекція потрапляє після тісного контакту з хворою людиною.
- При недотриманні гігієнічних процедур у вушній раковині. В цьому випадку створюються сприятливі умови для активізації та зростання мікробів.
- Після проведення ін’єкцій, хірургічних втручань в умовах стаціонару з недостатньою санітарною обробкою.
- Вживання м’ясних і молочних продуктів, заражених стафілококом.
Після інфікування патогенними мікроорганізмами порожнини вуха виникають певні симптоми, при виявленні яких необхідно відразу звернутися до лікаря.
Несвоєчасне звернення до лікаря і відсутність лікування можуть викликати небезпечні ускладнення, до яких відносять часткову або повну втрату слуху, запалення легенів, мастоїдит, менінгіт, остеомієліт та стафілококовий сепсис.
Лікування захворювання
Зокрема, бактерії виробляють фермент коагулозу, провокуючий потрапляння стафілокока в судини. При цьому розвивається згортання крові, виявляється стафілококовий сепсис. Бактерії вільно переміщаються по всьому організму, утворюючи запальні процеси в різних органах і тканинах.
Наявність стафілококової інфекції в органах слуху може викликати наступну симптоматику:
- Гострий біль при натисканні на козелок.
- Набряк і закладеність слухового проходу.
- Сверблячі відчуття.
- Підвищення температури тіла.
- Загальна слабкість.
- Виділення з вуха у вигляді слизу зеленого кольору і гною.
- Поява кірочок у вушній раковині.
- Пошкодження шкірних покривів в області вух.
Характерним проявом золотистого стафілокока є фарбування ураженого органу в жовтий колір.
При появі ознак інфекції потрібно відвідування вузького спеціаліста отоларинголога для постановки точного діагнозу.
- гемолітичний тип – провокує гнійні запальні процеси;
- сапрофітний тип – негативним чином впливає на сечовидільну систему;
- епідермальний тип – вражає шкірні покриви;
Бактерії мають округлу форму, розташовуються на поверхні шкіри і слизових оболонках. При зниженні імунітету можуть викликати затяжні запальні процеси.
Основна причина попадання мікроорганізмів на порожнину вуха – ігнорування правил особистої гігієни. Було виявлено, що до 45% населення планети – це носії стафілокока. При цьому людина може навіть не здогадуватися про це.
Іноді стафілокок може стати причиною гнійного отиту або поразки євстахієвої труби. На порожнини вуха може відбуватися поява кірочок, спайок. Можна побачити, як виглядає стафілокок у вусі, фото чітко демонструє протікає запальний процес з виділенням гною.
- гнійний запальний процес слухового апарату;
- поразка шкірних покривів вуха;
- на волосяних цибулинах розкладаються пробки;
- ураження клітин крові;
- алергічну реакцію.
За своїм зовнішнім виглядом скупчення бактерій схоже на грона винограду. Мікроорганізми стрімко адаптуються до багатьох лікарських препаратів, що істотно може ускладнити лікування.
Шляхи передачі можуть бути різні, наприклад, повітряно-крапельним шляхом після контакту з носієм. На зовнішню частину вуха бактерії нерідко потрапляють після дотику брудними руками.
Деякі фактори, що впливають на розвиток недуги:
- знижений імунітет внаслідок прийому лікарських препаратів, особливо антибіотиків;
- нестача вітамінів;
- запущені хронічні захворювання;
- погані екологічні умови в регіоні.
Також зараження може відбутися від неякісних продуктів харчування, через пил. Іноді виникає інфікування через кров, після уколів, ін’єкцій.
Часте переохолодження та зневоднення організму підвищує ризик розвитку інфекцій.
Саме небезпечне зараження – отримане в стаціонарі. Тому, що такі бактерії, виведені штучним шляхом, мають найбільш сильну опірність до більшості медикаментів.
До групи ризику відносять новонароджених малюків у пологових будинках. Навіть коли санітарно-гігієнічні норми в подібних установах виконуються, дитина відразу після народження найбільш вразливий перед такими недугами.
Наркомани відносяться до числа тих людей, у яких часто буває стафілокок у вусі, причини цього – постійне ослаблення організму після прийому заборонених препаратів.

Інфекція іноді розташовується в зовнішньому слуховому проході, а іноді — в середньому. У другому випадку розвивається середній отит. Осідає золотистий стафілокок у вусі через немиті руки, в основному хвороба вражає людей, що мають слабкий імунітет.
Профілактика захворювання спрямована на зміцнення імунітету, так як тільки сильний імунітет здатний допомогти організму чинити опір інфекції. Також не варто забувати вести здоровий спосіб життя, правильно харчуватися і уважно ставитися до особистої гігієни, що дасть можливість захистити себе від бактерій навіть при контакті з ними.
Стафілокок у вусі – досить поширений недуга. Ці бактерії знаходяться всюди в навколишньому середовищі, деякі з них не представляють особливої небезпеки для людини, інші ж можуть значно погіршити стан.
Золотистий стафілокок – це найнебезпечніший тип бактерій, що провокують запалення вуха. Щоб зрозуміти, як вилікувати стафілокок, необхідно розглянути причини розвитку і клінічну картину захворювання.
Попадання мікроорганізмів на порожнину вуха – ігнорування правил особистої гігієни
. Було виявлено, що до 45% населення планети – це носії стафілокока. При цьому людина може навіть не здогадуватися про це.
Розташування стафілококової інфекції у вусі
Після потрапляння бактерії на органи слуху, може початися отит.
Основною причиною розвитку є маленькі тріщинки і ранки на порожнини вуха через які патогенні мікроорганізми проникають всередину.
Саме небезпечне зараження – отримане в стаціонарі.
Тому, що такі бактерії, виведені штучним шляхом, мають найбільш сильну опірність до більшості медикаментів.
Профілактика
Золотистий стафілокок має широке поширення, неспецифічна профілактика допомагає запобігати зараженню їм. Існує ряд рекомендацій, до яких необхідно прислухатися.
- Важливо обмежувати контакти з хворими людьми.
- Не можна користуватися чужими банними приладдям та предметами гігієни.
- Перед їжею, після відвідування туалету або приходу з вулиці корисно мити руки з милом.
- Не варто колупати пальцем у вусі, не можна чесати слуховий прохід предметами, ліпшими під руку (сірниками, шпильками, ковпачок від ручки).
- У разі травмування вушної раковини потрібно тут же дезінфікувати ранку, а потім забезпечувати захист від забруднень.
- Корисно щодня проводити гігієну слухового апарату.
- При появі підозрілих симптомів необхідно звернутися до лікаря-отоларинголога.
- При перебігу захворювання фахівці радять суворо виконувати всі приписи.
- Не можна зловживати судинозвужувальними препаратами.
- Потрібно стежити за своїм здоров’ям, намагатися протягом усього життя підтримувати імунітет, правильно харчуватися, займатися спортом, загартовуватися, у сезон застуд стимулювати роботу захисних сил організму вітамінними комплексами.
- Важливо намагатися не допускати переохолодження та перегрівання організму, уникати подразників у вигляді харчових і хімічних алергенів (вони послаблюють імунну відповідь), підтримувати себе і свій будинок у чистоті.
Той, хто буде дотримуватися цих правил, зможе значно знизити ризики інфікування золотистим стафілококом. Якщо інфікування уникнути не вдалося, необхідно звертатися за медичною допомогою. Усунення проблеми на початковому етапі збільшує шанси на сприятливий результат.
Специфічна профілактика допомагає формувати штучний імунітет до бактеріального зараження. Для його створення використовується рідкий або таблетований анотоксин. Застосування вакцин, у складі яких є ослаблені або вбиті бактерії, що призводить до стимуляції вироблення антитіл, але тільки проти тих серотипів, з яких була виготовлена вакцина.
Золотистий стафілокок найбільш небезпечний для недоношених дітей, дітей молодшої вікової групи і літніх людей в силу ослабленої імунної захисту. Запалення на поверхні вуха, внутрішні патології, отити, інші відхилення сьогодні успішно лікуються.
Зрозуміти, що людське вухо атакували палички, стафілокока, можна, якщо уважно ставитися до свого організму і звертати увагу на підозрілі симптоми. Ще один спосіб розпізнати хворобу – це лабораторні дослідження проб, узятих з вушної раковини.
Дана процедура має назву бакпосів і проводиться виключно в умовах медичного закладу. Комплекс лікування передбачає не тільки позбавити пацієнта від захворювання, але і з’ясувати, з-за чого відбулося інфікування.
Такий підхід дозволяє уникнути появи рецидивів у майбутньому. До того ж, в залежності від причини хвороби, лікування може різнитися.
Заразитися золотистим стафілококом людина може наступними способами:
- Повітряно-крапельний спосіб. Зараження відбувається тоді, коли хвора людина кашляє або чхає в присутності здорового. Крім високого ризику заразитися, здорова людина може перетворитися в носія захворювання.
- Зараження аліментарним способом відбувається у разі ігнорування гігієнічних процедур, спрямованих на очищення равлики і слуховий порожнини. В умовах антисанітарії в порожнину вуха можуть проникнути бактерії стафілокока з продуктів життєдіяльності людей або тварин.
- Побутове зараження трапляється тоді, коли є тісний контакт з хворим або з переносником хвороби. Слід пам’ятати, що маються на увазі не тільки тілесні контакти, але і загальне користування предметами гігієни з хворим. Приміром, якщо здорова людина скористається рушником або зубною щіткою хворого.
- Медичний шлях зараження – це проведення хірургічних маніпуляцій в антисанітарних умовах.
Основна причина попадання мікроорганізмів на порожнину вуха – ігнорування правил особистої гігієни. Було виявлено, що до 45% населення планети – це носії стафілокока. При цьому людина може навіть не здогадуватися про це.
Іноді стафілокок може стати причиною гнійного отиту або поразки євстахієвої труби.
На порожнини вуха може відбуватися поява кірочок, спайок.
Золотистий стафілокок вражає шкірні покриви як у дорослих, так і у дітей. Для дитячого віку найбільш великий ризик, перехворіти цією недугою, тому, що організм ще дуже слабкий і не пристосований до багатьох бактерій. Таким чином, виникають фурункули, ячмені.
Саме небезпечне зараження – отримане в стаціонарі. Тому, що такі бактерії, виведені штучним шляхом, мають найбільш сильну опірність до більшості медикаментів.
Поява симптомів необхідно розпізнати якомога раніше, тоді лікування буде набагато ефективніше. Незалежно від того протікає золотистий або епідермальний стафілокок, лікування у вухах слід розпочати якомога швидше.
Для початку необхідно розглянути стан шкіри на внутрішній і зовні частини вуха, а також на супутні симптоми:
- висока температура тіла;
- загальна слабкість;
- головний біль;
- набряклість;
- сверблячі відчуття;
- закладеність і біль у вухах;
- шуми.
Виділення з вуха при стафилококке
Стафілококи також провокує інші не менш небезпечні хвороби:
- ураження мозкової оболонки;
- патології кісткових тканин;
- повна або часткова втрата слуху;
- пневмонія.
Однак найбільш небезпечним захворюванням вважають сепсис, коли бактерії потрапляють в кров, викликаючи незворотні наслідки. Гемолітичний стафілокок у вусі провокує розвиток гнійних висипань.
Визначати точний діагноз має право тільки лікар, вивчивши особливості перебігу хвороби, симптоми, провівши опитування хворого. Далі слід розробити максимально ефективну схему лікування для кожного випадку. При неправильної терапії стан пацієнта може тільки посилитися.
Коли виявляється стафілокок у вухах, лікування може ускладнити стійкість бактерій до різних антибактеріальних препаратів.
Мікроорганізми не гинуть при зневодненні, при впливі прямих сонячних променів. Навіть вплив етилового спирту не дозволяє вбити стафілокок.
Незважаючи на свою високу стійкість, бактерії відразу ж гинуть при кип’ятінні, а також якщо поріз або травму обробити звичайної зеленкою, то скоріше всього зараження не відбудеться.
Необхідність у місцевій терапії є тоді, коли утворюється тільки зовнішній отит. Прописуються краплі містять кортикостероїди, неоміцин.
При перебігу захворювання середньої ступеня, існує необхідність призначення антибіотиків. Крім того на місце ураження накладають спеціальний зігріваючий компрес.
Якщо не відбудеться яких-небудь поліпшень, проводиться прокол барабанної перетинки. При необхідності, пацієнту виписують препарати для зниження температури тіла, а також знеболювальні уколи.
Засоби народної медицини вже давно застосовуються в лікуванні стафілококової інфекції.
Проте такі заходи можуть бути прийняті тільки в якості додаткового лікування і тільки після консультації спеціаліста.
Застосовуються наступні методи:
- промивання вуха відваром звіробою допоможе виконати додаткову дезінфекцію перед подальшим застосуванням лікарських засобів. Ця трава є найсильнішим рослинним антибіотиком;
- кілька разів закапати у вухо розчин діоксидину. А потім ретельно просушити прохід за допомогою тампона або ватної палички. Таким чином повторити 2 рази за добу;
- можна застосовувати цілющі відвари ромашки, календули, але не варто забувати, що у деяких людей може виникнути алергічна реакція. Відвар повинен бути не більше і не менше Чим температура тіла людини.
Профілактика
Профілактичні заходи, які дозволять запобігти розвитку хвороби:
- дотримання всіх необхідних правил гігієни;
- своєчасна обробка травмованих ділянок антисептиком;
- не допускати розвитку карієсу;
- включити в раціон якомога більше корисної їжі;
- ретельно обробляти приміщення, виконувати генеральне прибирання;
- не вдаватися до послуг випадкових косметологів.
- щоб успішно подолати цю недугу, варто ретельно стежити за всіма вказівками лікаря.
Висновок
Не варто ігнорувати лікування стафілококової інфекції, тому, що ускладнення можуть бути дуже жахливими. Якщо не лікувати золотистий стафілокок в середньому вусі, то цілком ймовірно повністю втратити можливість чути.
Для того щоб уникнути захворювання або запобігти рецидив стафілокока у вухах, необхідно дотримуватися наступних правил:
- уникати контакту з зараженими людьми;
- користуватися тільки своїми засобами особистої гігієни;
- після прогулянок по вулиці і відвідування громадських місць обов’язково мити руки;
- своєчасно обробляти і дезінфікувати шкіру в вушних раковинах при травмах;
- постійно проводити гігієнічні процедури вух;
- добре мити фрукти і овочі перед їжею;
- пити тільки очищену воду;
- підтримувати імунітет;
- позбутися від шкідливих звичок;
- уникати переохолоджень.
- уникати контактів з хворими людьми;
- ніколи не застосовувати чужі гігієнічні приналежності;
- регулярно мити руки, особливо після відвідування громадських місць;
- при травмах шкіри вушної раковини обов’язково проводити дезінфекцію;
- регулярно виконувати гігієнічні процедури вушних раковин;
- ретельно мити овочі і фрукти перед їжею;
- використовувати для пиття тільки очищену воду;
- підтримувати високий рівень імунітету;
- уникати переохолоджень, шкідливих пристрастей і алергічних реакцій.
Проведення діагностики
Для виявлення патології в органах слуху фахівець проводить опитування і огляд пацієнта. Після призначаються спеціальні обстеження з використанням бактеріоскопічного та серологічного методу. Проведення таких лабораторних діагностик проводиться з використанням крові хворого.
Після отриманих результатів лікар визначає точний діагноз і призначає відповідне лікування.
Також рекомендується здача загального аналізу сечі, дослідження гнійних виділень і розгорнута імунограма.
Як лікувати

Лікування повинно проводитися під контролем лікаря
Основне завдання лікування золотистого стафілокока у вухах полягає в наступних етапах:
- нейтралізація впливу вірусів;
- запуск імуностимуляції організму;
- здійснення заходів безпеки щодо уникнення розповсюдження хвороби серед навколишніх людей через побутові предмети, тактильний і дихальний шлях;
- здійснення профілактичних заходів для попередження рецидивів.
Кожен з етапів включає в себе заходи, які здійснюються строго під спостереженням лікаря.
У разі ускладнень, якщо температура тіла тримається дуже високою і лікування не дає належного ефекту, проводиться тимпаноцентез. При даній процедурі проколюється барабанна перетинка. Саме тому краще не доводити до цього стану і вчасно звернутися за допомогою, тому як хворому в цьому випадку доведеться відчувати сильний біль.
Лікар, який здійснює цю процедуру, отримує рідина з вуха та аналізує, який саме вид збудника спричинив це захворювання, це робиться для коректування лікування. Крім того, усунення сприяє профілактиці спайок в вушному проході.
Не варто забувати, що золотистий стафілокок — це небезпечна і не завжди швидко піддається лікуванню інфекція, яка також може викликати ряд наслідків при недбалому відношенні і безграмотному підході до її лікування.
Медикаментозно
Медикаментозне лікування золотистого стафілокока включає в себе ряд заходів щодо усунення вірусу і відновлення захисних сил організму. Дуже часто на першій стадії захворювання пацієнта може здаватися, що нічого серйозного не відбувається і інфекція досить проста, однак це всього лише видимість.
Саме тому необхідно дуже швидко розпочинати медикаментозне лікування, прийом антибіотиків, особливо при важких стафілококових інфекціях, у вигляді ін’єкції Нафциллина, Цефалексину, Кліндаміцин, прийом імуностимуляторів Імудон та ІРС 19, використання мазі Бактробан, яка створює антибактеріальний ефект і благотворно впливає на стан шкірних покривів вуха.
Народні засоби

Існує кілька рецептів народної медицини, які можуть надати істотну допомогу. Слід пам’ятати, що вони є лише допоміжними і не можуть повністю нейтралізувати агресивну інфекцію. До основних з них відносяться:
- промивання вух сумішшю відвару звіробою і ромашки (столова ложка звіробою, 1 столова ложка ромашки на літр окропу; настоювати 15 хвилин і промивати область хворого місця;
- для закріплення ефекту ставляться тампони з 5 крапель настоянки прополісу і ватки, скрутити матеріал і акуратно відправити у вушний прохід на 15 хвилин;
- промивання вух розчином календули і шавлії (1 столова ложка суміші на літр окропу).
Не варто захоплюватися самолікуванням і наражати на небезпеку своїх близьких, негайно вирушайте до фахівців і здійснюйте боротьбу з цим захворюванням спільно з лікарем.
Методи лікування золотистого стафілокока
Медикаментозно
Медикаментозне лікування починається безпосередньо з перевірки бактерій на стійкість до препаратів використовуваного антибіотика. Застосовуються мазі і краплі з неоміцином, поліміксином, кортикостероїдами в складі, якими змочуються ватяні кульки і закладаються в хворий орган.
Щоб прибрати хворобливі прояви, лікарі призначають кварцування, сухе тепло і застосування знеболюючих препаратів. При складніших формах використовується загальна терапія, що включає в себе прийом антибіотиків і жарознижуючих засобів.
Народні засоби
Використання народних методів може полегшити симптоми, але не позбавити від стафілокока. Найбільш дієвими рецептами вважаються наступні:
- пюре з використанням смородини і абрикоса;
- різні трав’яні збори;
- настій з часнику;
- ванни з додаванням череди.
Слід пам’ятати, що такі методи є допоміжними, тому лікувати їх треба в комплексі з лікарськими засобами.
Чим лікувати стафілокок у вусі? Залежно від зони ураження терапія може бути загальною або місцевою. При зовнішньому отиті ефективно місцеве лікування. У цьому випадку прописуються вушні краплі, мазі, які містять неоміцин, колістин, поликсин або ж кортикостероїди.
Закапувати препарати безпосередньо у вушний прохід не рекомендується, краще всього змочити ліками ватний або марлевий відріз і обережно ввести в вухо. Повторювати таку процедуру необхідно три-чотири рази на день.
Якщо больові відчуття не проходять, рекомендовано застосовувати сухе тепло, кварцування і таблетки. Популярністю користується гентамициновая мазь, нею необхідно обробляти вушні канали протягом тижня.
Загальна терапія проводиться при середньому отиті. У цьому випадку призначається курс антибіотиків, найчастіше ампіцилін. Також в терапію входять жарознижувальні препарати і знеболюючі засоби, фахівець може порекомендувати зігріваючі компреси.
При відсутності поліпшень протягом двох-трьох діб може бути призначена тимпанопунция або тимпаноцентез. Це прокол барабанної перетинки, після якого вушний канал звільняється від ексудату, при цьому рідина береться для дослідження і визначення стійкості до різних видів антибіотиків, після чого лікування коректується.
Під час курсу прийому лікарських препаратів не можна робити перерву або припиняти лікування передчасно, орієнтуючись на поліпшення стану. Це може привести до адаптації стафілокока до дії лікарського засобу.
Часто його зустрічають на медичних інструментах, предметах побуту і навіть дитячих іграшках.
Золотистим він називається з-за свого світіння
.
Золотистий стафілокок найчастіше проявляється при зниженій імунній системі. Цьому сприяють наступні причини
:
- Довгий застосування антибіотиків.
- Сильні стреси.
- Вживання великої кількості солодкого, жирного і мучного.
- Нестача вітамінів.
- Зміна складу мікроорганізмів у кишечнику.
- Відсутність гігієни.
У дітей інфекція може з’явитися, якщо дитина народилася сильно недоношеним
, а також:
- тріщини на сосках матері;
- годування дитини штучними сумішами;
- пізніше прикладання малюка до грудей.
У дітей
стафілокок може бути викликаний поразкою пупкової ранки
мікробами, а також:
- набряк пупкового кільця;
- переповнення кров’ю судин кровоносної системи поряд з пупком.
Симптоми
золотистого стафілокока у вусі
різні. Це може бути сильний свербіж і печіння. А також відзначається виділення гною і слизу.
В першу чергу
необхідно виявити причину і місце розташування захворювання. Найчастіше стафілокок з’являється у вухах. Важливо вчасно помітити, так як пізніше діагностування може викликати ускладнення у вигляді глухоти.

Після огляду вуха, лікар призначає лікування
. У нього входить застосування антибіотиків і зовнішніх мазей.
У складі препарату відзначаються хіміотерапевтичні речовини, що дозволяють безпечно видалити вогнище запалення.
Закапуйте препарат по чотири краплі в кожне вухо
. Перед застосуванням зігрійте пляшечку в долонях. Це допоможе уникнути неприємних відчуттів у вусі.
Також необхідно використання гентаміциновою мазі
. Курс лікування повинен становити не менше двох тижнів.
Нанесіть препарат на зовнішнє вухо пацієнти тонким шаром. Використовуйте медикамент три рази в день.
Крім цього, придбайте стафілококовий бактеріофаг в ампулах
. Це иммунобиологический препарат, здатний ліквідувати вогнище інфекції. Для використання ліки необхідно заздалегідь прочистити зовнішнє вухо.

При вирішенні спеціаліста, хворий може скористатися засобами місцевої дії. У них входять прийняття відварів, застосування перекису водню та інших розчином.
Ефективно борються з інфекцією засобів проти мікробів. Це можуть бути різні спиртові настої або відвари з трав.
звіробій
. Сучасна медицина використовує висушену траву звіробою для складання багатьох ліків.
Для приготування відвару вам знадобиться 15 грам трави
. Залийте рослина один склянкою окропу. Залиште настоянку на дві години в темному місці. Після цього процідіть відвар і закопуйте в обидва вуха по п’ять крапель.
Результативною дією володіє настій з ромашки.
Для його виготовлення знадобиться 2 великі ложки
кольори. Попередньо їх слід подрібнити. Залийте отриману суміш склянкою горілки
і щільно закрийте.
Помістіть відвар в темне місце на кілька годин. Потім відіжміть сировину і процідіть. Закапуйте настоянку в кожне вухо по три краплі протягом тижня.
Цілющими властивостями володіє шавлія
. Для приготування відвару вам знадобиться одна ложка листя шавлії. Залийте рослина однією склянкою окропу
.
Щільно закрийте кришкою і дайте настоятися протягом 30
хвилин. Потім приймайте по дві краплі в кожне вухо через кожні п’ять годин.
Основною причиною розвитку стафілококової інфекції є ослаблення імунної системи людини. Вплив на цей процес впливають такі чинники:
- Наявність хронічних недуг.
- Тривалий прийом антибіотиків і імунодепресантів.
- Нестача вітамінів.
- Простудні та вірусні захворювання.
- Постійні стресові ситуації.
Інфікування стафілококом може відбутися в будь-якому віці, але особливо до цього схильні літні люди і діти.
Підставою для вибору способу терапії служить місце локалізації бактерій в слуховому органі. При ураженні зовнішнього відділу вуха для лікування застосовуються лікарські препарати місцевого впливу. Якщо запальний процес торкнувся внутрішню частину слухового проходу, призначається пероральний прийом медикаментів.

При інфікуванні золотистим стафілококом зовнішнього вуха доктором призначаються такі лікувальні процедури:
- Застосування крапель, у складі яких є поликсин, неоміцин або колістин. В якості крапель використовуються такі препарати, як Дексона або Поліміксин. Ліки наноситься на ватний тампон і встановлюється в слуховий прохід. Така процедура проводиться 3 – 4 рази на добу. Також можливе використання мазі з кортикостероїдами Гідрокортизон, Адвантат, Белогент.
- Обробка зовнішнього слухового відділу вуха гентаміциновою маззю.
- Для зняття больових відчуттів призначаються знеболюючі препарати, кварцування і сухе тепло.
Курс місцевого лікування становить від 12 до 14 днів.
Проникнення бактерій в середнє і внутрішнє вухо вимагає застосування загальної терапії з використанням антибактеріальних препаратів. В основному призначається антибіотик Ампіцилін з тривалістю прийому не менше 10 днів.
Додатково до базисної терапії застосовуються жарознижуючі і знеболюючі засоби. Для місцевого впливу на уражений орган накладають зігрівальні компреси.
У випадку коли використання антибактеріальних засобів не покращує стан пацієнта, доктором приймається рішення про проведення процедури з проколом барабанної перетинки. В результаті таких дій слуховий прохід звільняється від скупчення гною. Отримані виділення досліджують для підбору найбільш відповідного лікарського засобу.
Своєчасне і правильне лікування дозволить уникнути небезпечних ускладнень і поява рецидивів, а знизити ризик інфікування допоможе дотримання попереджувальних заходів.
Як ускладнення може почати розвиватися глухота або внутрішньочерепна інфекція. Лікування проводиться антибіотиками і зовнішніми мазями.

Останні використовуються тільки при зовнішньому отиті. Як правило, застосовуються препарати неоміцину, поліміксину, а також кортикостероїди.
При розвитку середнього отиту виписуються хворому антибіотики. Широко в даному випадку застосовується пеніцилін. Як правило, курс лікування займає не більше 10 днів. Якщо є необхідність, то хворому дають також засоби для зниження спека і знеболюючі. Крім того, можуть використовуватися компреси для зігрівання.
Якщо через дві доби від початку лікування біль не пройде і температура не спаде, то можна буде робити таку процедуру як тимпаноцентез. Це досить боляче, так як під час неї барабанна перетинка проколюється.
Але тільки таким чином у лікаря є можливість отримати рідина з вуха і проаналізувати її, щоб зрозуміти діючий збудник та провести коригування лікування. Даним методом в деякій мірі дренується середнє вухо і попереджається можливість появи спайок і рідини.
Більш того, для лікування вушного стафілокока можна користуватися народними методами. Наприклад, промивання вух за допомогою трав і настоїв. Використовується для цього звіробій, ромашка, календула і шавлія. Тільки тут варто враховувати той факт, що позбутися від золотистого стафілокока одними відварами не вийде.
Якщо відсутнє адекватне і правильне лікування, то тоді отит може дійти до скроневих кісток, що спровокує запалення їх клітин. Крім того, це призведе до руйнування барабанної перетинки, внаслідок чого людина повністю або частково втрачає здатність чути.
- Застосування крапель
, у складі яких є поликсин, неоміцин або колістин. В якості крапель використовуються такі препарати, як Дексона або Поліміксин. Ліки наноситься на ватний тампон і встановлюється в слуховий прохід. Така процедура проводиться 3 – 4 рази на добу. Також можливе використання мазі з кортикостероїдами Гідрокортизон, Адвантат, Белогент. - Обробка зовнішнього слухового відділу вуха гентаміциновою маззю.
- Для зняття больових відчуттів призначаються знеболюючі препарати, кварцування і сухе тепло.
Профілактичні заходи
Щоб попередити розвиток стафілококової інфекції необхідно виконувати нескладні правила, до яких відносять:
- Зміцнення імунітету за допомогою здорового способу життя, загартовування організму і прийому полівітамінів.
- Дотримання правил особистої гігієни.
- Підтримання чистоти вушних раковин.
- Обмеження контактів з інфікованими людьми.
- Своєчасне звернення до фахівця при появі первинних симптомів.
Ознайомлення і виконання профілактичних заходів допоможе зміцнити здоров’я і уникнути виникнення серйозного захворювання.
Щоб уникнути тривалого лікування дуже небезпечної хвороби, важливо дотримуватися профілактичні заходи, які допоможуть завжди залишатися здоровим і повним сил. Зокрема, рекомендується:
- зміцнювати імунітет, щоб не допустити проникнення хвороботворних бактерій в організм;
- дотримуватися правильного харчування;
- відмовитися від шкідливих звичок;
- вчасно чистити слуховий прохід і вушні раковини від пилу і бруду;
- захищати вуха від переохолодження в холодну пору.
В організмі і на шкірних покривах є багато бактерій, серед яких і стафілокок. Мікроорганізми в звичній обстановці здатні нашкодити організму, проте при створенні сприятливих умов для їх розвитку бактерії розмножуються і надалі вражають тканини, викликаючи запалення і патологічні процеси.
Протягом життя людського організму доводиться стикатися з безліччю різних хвороботворних організмів. Вони атакують людину з різних сторін: потрапляють всередину з продуктами харчування і водою, літають по повітрю і проникають в носоглотку при вдиху, приєднуються від хворих людей.
Крім цього, бактерії живуть безпосередньо в самому організмі людини. Вони можуть цілком спокійно існувати там до того моменту, поки не починають активно розмножуватися під впливом несприятливих факторів зовнішнього середовища і ослабленого імунітету, несучи загрозу людському організму.
Причини розвитку захворювання
Ураження золотистим стафілококом – захворювання дуже серйозне, тому не треба займатися самолікуванням або намагатися вилікувати дитину народними засобами.
Слід негайно звернутися до лікаря-отоларинголога, щоб він поставив точний діагноз і призначив необхідний курс лікування. Вчасно зупинена розвиток стафілокока обійдеться без ускладнень і усунути його буде нескладно. При запущеному захворюванні наслідки можуть бути непередбачуваними.
Якщо не лікувати стафілококову інфекцію, то активний процес розмноження бактерії у вусі може призвести до наступних ускладнень:
- зниження або повної втрати слуху (внаслідок ураження барабанної перетинки);
- поширення запального процесу на головний і кістковий мозок, що спричинить за собою розвиток менінгіту або остеомієліту;
- інфекційно-запальної патології в сосцевидном кістковому відростку, що знаходиться позаду вуха;
- пневмонії.
Запущена стафілококова інфекція поширюється на весь організм, а вилікувати спровокований нею сепсис практично неможливо.
Внутрішні патології та інші хвороби, викликані золотистим стафілококом у вухах, вимагають своєчасного лікування. Чим раніше усунути захворювання, тим менше ризик, що бактерія пошириться за межі вушної раковини. В іншому випадку є ризик розвитку серйозних ускладнень, таких як:
- Менінгіт. Відбувається зараження і запалення головного мозку, хвороба небезпечна і може закінчитися летальним результатом.
- Сепсис – при попаданні бактерії та продуктів її життєдіяльності в кров існує ризик зараження крові. При неправильному і несвоєчасному лікуванні може призвести до смерті людини.
- Синдром токсичного шоку – гостра реакція організму на поширення інфекції.
Крім цього, захворювання може перерости в хронічну форму, в такому випадку інфекція виробить імунітет на застосовувані проти неї засоби.
Симптоми і ознаки ураження стафілококом у вусі
Важливо! Якщо вас турбують отити, запишіть рецепт ефективного засобу від вушних захворювань … Читати подробиці
Стафілокок, вражаючи вухо, здатний викликати чимало серйозних ускладнень, таких як пневмонія, менінгіт або глухота. Лікування повинно бути розпочато негайно.
Стафілокок є нерухомою бактерією сферичної форми. У природі існує величезна кількість представників цього роду мікроорганізмів. Одні з них умовно – патогенні і не завдають людині ніякої шкоди.
Інші, навпаки, ледве потрапивши в організм, починають посилено розмножуватися, створюючи в місцях своєї локалізації вогнища запалення. Якщо у людини сильний імунітет, його організм зможе боротися з інфекцією, коли ж він ослаблений, бактерії можуть оселитися в будь-якому органі. Особливої уваги потребує стан, коли виявлений стафілокок у вусі.

Існує 4 види патогенних стафілококів, завдають серйозної шкоди людському організму, але найбільш небезпечним з них є золотистий стафілокок. Це бактерія, яка швидко мутує і тому погано піддається лікуванню антибіотиками.
У годуючих матерів золотистий стафілокок селиться в мікротріщинах на сосках і навколо вивідних молоко проток, будучи причиною деяких видів маститів.
Ураження внутрішніх органів може призвести до захворювань сечостатевої системи, серця, мозку та зараження крові. Навіть якщо людина перехворіла і позбувся стафілокока, це не дає впевненості, що він не залишиться носієм бактерії або не захворіє повторно.
| Назва патології
|
Локалізація | Причини | Клінічні прояви
|
Тривалість хвороби
|
Особливості лікування
|
| Нарив в кістково-хрящевом каналі. Гнійно-запальна реакція розвивається на тій ділянці каналу, де можуть рости волосся і утворюватися шкірне сало. | Людина, колупаючи в юшці сірниками або будь-якими іншими твердими предметами, створює ранки, які стають відкритими воротами для бактерій. Колупаючи в вусі нігтями, кожен з нас збільшує ризики інфікування. | Нарив, що формується в слуховому каналі, викликає появу болю, яка віддається в різні частини голови. Її формуванню сприяє збільшення тиску гною в фурункулі. Воно впливає на оболонку хряща, в ній знаходиться багато нервових корінців. Біль посилюється при відкриванні рота або відтягування вуха. Лімфатичні вузли збільшуються, температура тіла піднімається до 38 градусів, хворий скаржиться на загальне нездужання. Слух при такому запаленні не пропадає. | Близько тижня | Хворому призначаються антибіотики пеніцилінової групи. Після того, як гнійник розкривається, у вухо вставляється ватний тампон, змочений у розчині пеніциліну і новокаїну. Для знеболювання застосовується Метамізол. До загальної терапії обов’язково підключаються фізіологічні процедури. Хороші результати показує вплив електромагнітними полями і ультрафіолетом. При рецидивуючому перебігу хворому призначаються ін’єкції суспензії стафілококового токсоида. | |
| Змішаний гнійно-зовнішній отит | Запалюється слизова оболонка слухової труби, в результаті цього її стінки товщають, барабанна порожнина поступово заповнюється гноєм і розбухає. Тиск гнійної рідини провокує прорив барабанної перетинки. В результаті гній виливається назовні. | Зараження шкіри золотистим стафілококом при механічному, хімічному, грибковому термічному ушкодженні епідермісу. | При гострому перебігу на початковому етапі відзначається почервоніння тканин, поява свербежу і виділень, які мають гнильний запах. При натисканні пальцем виникає виражена болючість. У слуховому проході нерідко з’являються пухирці, після прориву вони покриваються сірими корочками, які дуже важко знімаються. | У кожного по-різному. Дозрівання гною триває близько тижня, якщо потім при позитивній динаміці відновлюється біль у вусі, це свідчить про застій гнійної рідини або про розвиток ускладнення у вигляді запалення соскоподібного відростка. Тоді захворювання затягується на три-чотири тижні. | Кірки розм’якшуються за допомогою 3% розчину Н2О2, після їх видалення пошкоджена шкіра обробляється емульсією, у складі якої є антибіотики. Барабанна порожнина промивається борним спиртом або розчином фурациліну. Після цього проводиться вдування порошку борної кислоти. Хворому призначаються ін’єкції антибіотиків широкого спектру дії, паралельно з основним лікуванням здійснюється санація носоглотки. Свербіж знімається білої ртутної маззю.При відсутності поліпшення проводиться хірургічна операція. |
| Гострий тубоотит | Запалюється слухова труба і барабанна порожнина. | Інфекція потрапляє у вухо через верхні дихальні шляхи. | З’являються слизові виділення, слух знижується, але після высмаркивания або при зевке тимчасово відновлюється. Це вірна ознака патології. | Кілька діб | Інфекція пригнічується антибіотиками, запалення знімається фізіопроцедурами, слух відновлюється за допомогою масажу барабанної перетинки повітрям. |
| Серозний отит гострої форми | Стафілококове ураження слизової носа або горла. У вухо бактерії потрапляють через євстахієву трубку. | Запалення зачіпає стінки слухової труби, в процесі нього вони замикаються, порушується вентиляція вуха, відтік гною стає неможливим. На барабанну перетинку впливає негативний тиск, формується серозний ексудат. Він має консистенцію холодцю. Хворі скаржаться на присутність шуму у вухах, ослаблення слуху. Їм здається, що при нахилі голови у вусі починає переливатися вода. Після видалення ексудату з барабанної пазухи слух повністю відновлюється. | Тривало | Спочатку лікується запалення в горлі або в носі. Для цього антибіотики не використовуються (вони можуть спровокувати затвердіння секрету, що тільки погіршить симптоматику). Запалення знімається протинабряковими краплями. Вхід в слухову трубу обробляється Мірамістином. В порожнину вуха за допомогою катетера вводиться трипсин. Протеолітичний фермент сприяє розрідженню секрету. Набряк знімається електрофорезом. Якщо медикаментозна терапія не допомагає, проводиться тимпанопункция. |
Бактерії оточують нас скрізь: вони живуть у повітрі, в землі, і навіть в організмі живих істот, не заподіюючи ніякої шкоди. Є особлива група бактерій, які здатні оселитися у внутрішніх органах тварин та людей і нашкодити. Серед таких можна назвати стафілокок у вухах – це бактерії, які оселилися в організмі людини.
В цілому, бактерії стафілокока здатні завдати велику загрозу для здоров’я або навіть життя, а також є провокаторами хвороб. Їх можна поділити на кілька підгруп:
- Гемолітичні. Призводять до гнійних запалень.
- Сапрофитные. Локалізуються в сечостатевих органах.
- Епідермальні. Впливає на шкіру і слизові оболонки.
- Найбільш небезпечним для організму є золотистий стафілокок.
Якщо зупинитися на останній групі детальніше, то називають його «золотим» за те, що при його впливі зона ураження набуває золотистий колір, а він може вражати майже всі органи і тканини. Саме він і вражає вуха у людини.
Диференціальна діагностика
Досвідчений лікар-отоларинголог здатний поставити попередній діагноз на основі первинного огляду та збору анамнезу захворювання. На даному етапі його завдання – визначити місце локалізації запального процесу, тяжкість захворювання і форму розвитку патології.
Їх головне завдання – ідентифікувати збудника і визначити його резистентність до антибактеріальних препаратів. Вирішення останньої проблеми дає можливість підбирати антибіотики і виробляти ефективну терапію, здатну запобігти перехід гострої фази в хронічну.
Для цього з вуха береться мазок і здійснюється бактеріологічний посів. Результати аналізу лікуючий лікар може побачити вже на четверту добу. Присутність в мазку епідермального стафілокока вважається нормою, золотистого — немає, лікування повинно допомогти придушити активність цього патогенного мікроорганізму.
Народні засоби
Лікування золотистого стафілокока засобами народної медицини може бути досить ефективним, але в будь-якому випадку воно повинно носити допоміжний характер по відношенню до традиційного лікування. Містяться в рослинах активні речовини пригнічують патогенні мікроорганізми, знімають біль і запалення, дезінфікують уражену ділянку і підвищують імунітет.

Кілька порад застосування народних засобів:
- Звіробій. Настоєм або відваром звіробою промивається попередньо очищений від сірки прохід для зменшення запалення. Раціонально це робити незадовго до основного прийому ліків. Звіробій – сильний природний антибіотик і хороший для місцевого застосування.
- Розчин діоксидину. 4 краплі розчину капають в слуховий канал, через 10-15 хвилин висушують його ватною паличкою. Процедура повторюється двічі на день (зранку і ввечері).
- Відвари ромашки, календули, шавлії добре підтримують класичну терапію. Потрібно тільки звертати увагу на те, що деякі трави можуть викликати у людей алергічну реакцію. Відвар повинен бути приблизно температури тіла людини, більш холодна рідина призведе до звуження судин і ослаблення дії ліків.
Зменшити ймовірність захворювання бактеріальної інфекцією можна, використовуючи прості правила:
- заняття фізкультурою і здоровий спосіб життя;
- правильне і повноцінне харчування;
- дотримання правил особистої гігієни і чистоти в оселі;
- своєчасне усунення захворювань зубів і носоглотки.
Народна медицина при лікуванні стафілокока у вусі досить ефективна, але вона може носити лише допоміжний характер по відношенню до традиційної терапії. Цілющі рослини містять активні речовини, які здатні знімати біль і запалення, пригнічує хвороботворні бактерії, дезінфікувати уражену ділянку шкіри і позитивно впливати на імунітет.
Ось кілька порад застосування народних засобів:
- Звіробій. Відвар і настій з цієї рослини використовують для промивання вух, попередньо очищених від сірки. Це засіб добре знімає запалення. Найкраще таке промивання робити перед прийомом основного ліки. Звіробій вважається відмінним природним антибіотиком і ефективний при місцевому застосуванні.
- Розчин діоксидину. Чотири краплі ліки закапують у вухо, через 10-15 хвилин висушують його ватною паличкою. Процедуру повторюють два рази на добу – вранці і ввечері.
- Настої і відвари ромашки, шавлії, календули також можуть бути використані як доповнення до основної терапії. Потрібно враховувати, що деякі види трав викликають алергічні реакції. Відвар повинен бути приблизно температури тіла людини,
- Потрібно тільки звертати увагу на те, що деякі трави можуть викликати у людей алергічну реакцію. Відвар або настій повинен бути приблизно температури тіла людини. Холодне засіб призведе до звуження судин і не принесе потрібного ефекту.
Засоби народної медицини активно використовуються в терапії стафілококових інфекцій, однак вони можуть застосовуватися тільки в якості допоміжної терапії після консультації з лікарем. Склад деяких лікувальних трав містить речовини, які здатні пригнічувати активність хвороботворних бактерій.
До них відноситься звіробій, ромашка аптечна і календула. З них готуються відвари і настої, за допомогою яких потім виробляється промивання запаленої трубки до прийому лікарського засобу. Прохід попередньо ретельно очищається від сірки.
Клінічна картина
Наявність стафілокока у вусі не може протікати безсимптомно. Такі ознаки є вагомим приводом звернутися до лікаря для уточнення діагнозу:
- набряклість слизових оболонок, закладеність вух і шуми в голові;
- хворобливі відчуття при натисканні на козелок;
- свербіж зовнішнього слухового проходу;
- виділення з вушних каналів зеленої слизу з відразливим запахом;
- гнійні виділення з вух;
- скоринки у вушній раковині;
- лущення вуха;
- дефекти і запалення епідермісу вуха;
- ознаки інтоксикації організму;
- підвищена температура тіла.
Зона ураження при цьому змінить свій звичайний колір на жовтий з золотистими відливами.
За найменшої підозри на золотистий стафілокок у вусі лікування повинно бути негайним. Будь бездіяльність в такій ситуації може спричинити за собою такі небезпечні ускладнення, як:
- запалення бронхолегеневої системи;
- часткова або повна втрата здатності чути;
- запалення соскоподібного відростка;
- запалення головного мозку та його оболонок;
- сепсис будь-якої з систем організму людини.
Існує помилкова думка, що захворювання може розвинутися тільки в вухах у дітей. Насправді цього недугу схильні всі люди без винятку.
Поява симптомів необхідно розпізнати якомога раніше, тоді лікування буде набагато ефективніше. Незалежно від того протікає золотистий або епідермальний стафілокок, лікування у вухах слід розпочати якомога швидше.
Якщо виявляються стафілокок у вусі, симптоми, слід терміново звернутися до Лора.
Однак найбільш небезпечним захворюванням вважають сепсис, коли бактерії потрапляють в кров, викликаючи незворотні наслідки. Гемолітичний стафілокок у вусі провокує розвиток гнійних висипань.
Про хвороби
Стафілококи – це бактерії круглої форми, які розташовуються у вухах і слизових оболонках. При слабкому імунітеті вони можуть викликати безліч захворювань і запалень. Бактерія потрапляє в організм різними шляхами, найпоширенішим вважаються брудні руки.
Стафілококова інфекція має близько трьох десятків штамів, які відрізняються своїм впливом на людину. Деякі з них не здатні завдати шкоди, але більшість викликають серйозні захворювання із запаленнями і гнійними виділеннями.
Найпоширенішим вважається золотистий стафілокок. Він може вразити будь-який орган, у тому числі і вухо. Тому цей вид бактерії вважається найнебезпечнішим.
Найчастіше золотистий стафілокок у вусі викликає зовнішній отит, лікування якого повинно бути своєчасним, поки інфекція не поширилася на інші органи і тканини. Також стафілокок може викликати розвиток фурункула вушної раковини або бешихове запалення.
- Імунні захворювання, в т. ч. ВІЛ і СНІД.
- Переохолодження організму.
- Нестача вітамінів.
- Ослаблення захисних функцій організму.
- Цукровий діабет.
- Проблеми з ендокринною системою.
- Недотримання правил гігієни.
- Шкідливі звички.
- Наявність хронічних захворювань.
- Зневоднення організму.
- Тривале використання судинозвужувальних крапель.
- Вірусні та простудні захворювання.
- Травми і пошкодження слизової оболонки або шкіри.
Симптоми золотистого стафілокока у вусі найчастіше проявляються у немовлят, маленьких дітей і літніх людей, так як в ці періоди в організмі людини ослаблений імунітет.
Стафілококи – це круглі бактерії, розташовані у вухах і слизових оболонках. При слабкою імунною системою можуть спровокувати появу безлічі запалень і захворювань.
Інфекція може потрапити у вухо різними шляхами. Найпоширеніший випадок, коли людина доторкається до органу слуху брудними руками.
А також спровокувати появу бактерії може нестача вітамінів або сильно ослаблений імунітет.
Таким чином, стафілокок може викликати серйозні захворювання. Наприклад, гнійний отит в середньому вусі або запалення євстахієвої труби.
Крім цього, у вусі можуть з’явитися гнійні виділення і утворення спайок і корочок.
Багато людей думають, що стафілокок може з’явитися тільки в вухах у дітей. Проте, ця думка помилкова.
Перед визначенням необхідного лікування, зверніть увагу на симптоми захворювання. У першу чергу порушується шкірний покрив у вухах. Крім цього, відзначаються такі симптоми, як:
- підвищена температура;
- слабкість;
- сильні головні болі;
- набряки;
- поява слизу;
- біль у зовнішньому вусі;
- закладеність у вухах.
Стафілокок провокує появу небезпечних захворювань, таких як:
- запалення мозкових оболонок;
- інфекційне запалення кісткової тканини. В тому числі захворювання кісток і самого кісткового мозку;
- часткова втрата слуху або приглухуватість;
- запалення легенів.
Однак найбільш небезпечним захворюванням вважається загальне зараження організму хвороботворними мікробами, які потрапили в кров.
При легкому захворюванні лікар прописує препарати з антибіотиками, до складу яких входить неоміцин. Він міститься в медикаменту під назвою «Дексона».
Також ефективним дією володіють групи антибіотиків з вузьким спектром активності, під назвою «Поліміксин».
Використовуйте перераховані засоби у відповідності з інструкцією і з застосуванням турунд. Так ліки буде діяти більш ефективно.
Курс лікування не повинен превышатьдней.
Якщо протягом усього курсу лікування у пацієнта підвищена температура, приймайте жарознижуючі медикаменти. А також дозволяється застосування зігріваючих компресів.
Зверніть увагу, якщо після застосування антибіотиків хворому не стало краще, необхідно зробити прокол барабанної перетинки.
Дана процедура досить болюча і проводиться за крайньої необхідності.
В результаті операції у людини виводиться рідина, яку обстежують для уточнення діагнозу.

Під час лікування стафілокока, важливо стежити за харчуванням хворого. Свіжі фрукти та овочі допоможуть ефективного одужання і підвищать стан імунітету людини.
Також фахівці радять приймати велику кількість води. При отруєнні організму отруйними речовинами, вода допоможе очистити організм.
Дуже багато людей цікавляться питанням, чи передається стафілокок повітряно-крапельним шляхом?
Інфекція проникає в організм через шкіру або слизовий покрив.
Ризик захворювання збільшується, якщо у людини відкриті рани або опіки. А також хвороба може пройти через очі або навіть через кров.
Слідкуйте за стерильністю матеріалів при перев’язках або використанні медичних інструментів, так як інфекція може перенестись і через них.
Ретельно мийте овочі та фрукти.
Відзначені випадки передачі інфекції через статеві шляхи.
Велика ймовірність попадання інфекції при чханні або кашлі.
Немовляті бактерія може передатися через молоко матері. Варто зазначити, при появі тріщин на сосках, у матері може утворитися гнійний мастит.
Потрапляючи у стравохід з молоком матері, у дитини розвивається дисбактеріоз. Надалі у малюка на шкірному покриві з’являється висип, а важких випадках – фурункули.
Стійкість
Лікування золотистого стафілокока у вусі ускладнює його стійкість до активних речовин і лікарських препаратів. Інфекція зберігає свою активність при високих температурах, не боїться прямих сонячних променів і зневоднення.
Крім цього, стафілокок здатний проникати крізь шкіру в судини, використовуючи особливий фермент – коагулазу, і згортати кров. Це загрожує сепсисом і переміщенням інфекції по всьому організму. При попаданні через слизові оболонки носоглотки в легені бактерія може викликати важковиліковну пневмонію.
Стафілокок гине при кип’ятінні. І, незважаючи на стійкість до деяких видів антибіотиків, він боїться анілінових барвників. Тому, обробивши рану зеленкою, можна отримати досить надійний бар’єр на шляху проникнення стафілокока.
Як передається
Визначити наявність стафілокока у вухах можна за допомогою взяття проби для бакпосіву або за вже набутим ознаками. Але лікування передбачає не тільки зусилля, спрямовані на те, щоб знищити бактерію, але і на з’ясування причин зараження.
Золотистий стафілокок у вухах у дорослих і дітей з’являється наступним чином:
- Контактно-побутовий шлях. Інфікування відбувається шляхом тактильного контакту з переносником захворювання, а також з його особистими речами – це найпоширеніший шлях зараження. Якщо людина буде користуватися рушником хворого бешиховим запаленням шкіри, то з великою ймовірністю незабаром зіткнеться з такою проблемою.
- Повітряно-крапельний шлях. Інфікування відбувається через чхання чи кашель зараженої людини.
- Аліментарний шлях. Передбачає потрапляння в організм інфекції через органи, що входять в систему травлення, виділення бактерій також відбувається через кишечник.
- Пил. Вона включає в себе частинки епітелію, бруд і мікроби, які можуть довго залишатися життєздатними в таких умовах і проникнути у вушну раковину при недотриманні правил підтримання чистоти.
- Медичний шлях. Інфікування відбувається при хірургічному лікуванні і пошкодження вуха у нестерильних умовах.
Висновок
Лікування золотистого стафілокока у вусі необхідно починати якомога швидше. Його не можна залишати без уваги. Бактерія може викликати безліч небезпечних захворювань і значно знизити слух. Для повного лікування може знадобитися багато часу, але досвідчений лікар завжди намагається призначити саму ефективну терапію, для того щоб швидше повернути здоров’я людини.
Стафілокок, особливо золотистий, не можна залишати без уваги. Він може принести безліч додаткових захворювань, а також помітно знизити слух людини.
Для його лікування потрібно багато часу і старань. Досвідчений лікар, оглянувши вуха, призначить індивідуальне лікування стафілокока у вусі, здатне якомога швидше повернути здоров’я пацієнта.
Важливо займатися профілактикою захворювання.

У нього входить зміцнення організму шляхом загартовування та здорового способу життя. Слідкуйте за харчуванням і уважно ставитеся до правил гігієни.
Не варто ігнорувати лікування стафілококової інфекції, тому, що ускладнення можуть бути дуже жахливими. Якщо не лікувати золотистий стафілокок в середньому вусі, то цілком ймовірно повністю втратити можливість чути.
Щоб убезпечити себе від таких наслідків необхідно прагнути дотримуватися здоровий спосіб життя. Щорічно проходити повне обстеження для виявлення прихованих проблем.
Вконтакте
Копіювання матеріалів сайту можливе без попереднього погодження у разі встановлення активної індексованою посилання на наш сайт.
Довідник основних ЛОР захворювань та їх лікування
https://www.youtube.com/watch?v=PonyXWbhA8o watch
Вся інформація на сайті є популярно-ознайомчої і не претендує на абсолютну точність з медичної точки зору. Лікування обов’язково повинне проводитися кваліфікованим лікарем. Займаючись самолікуванням ви можете нашкодити собі!